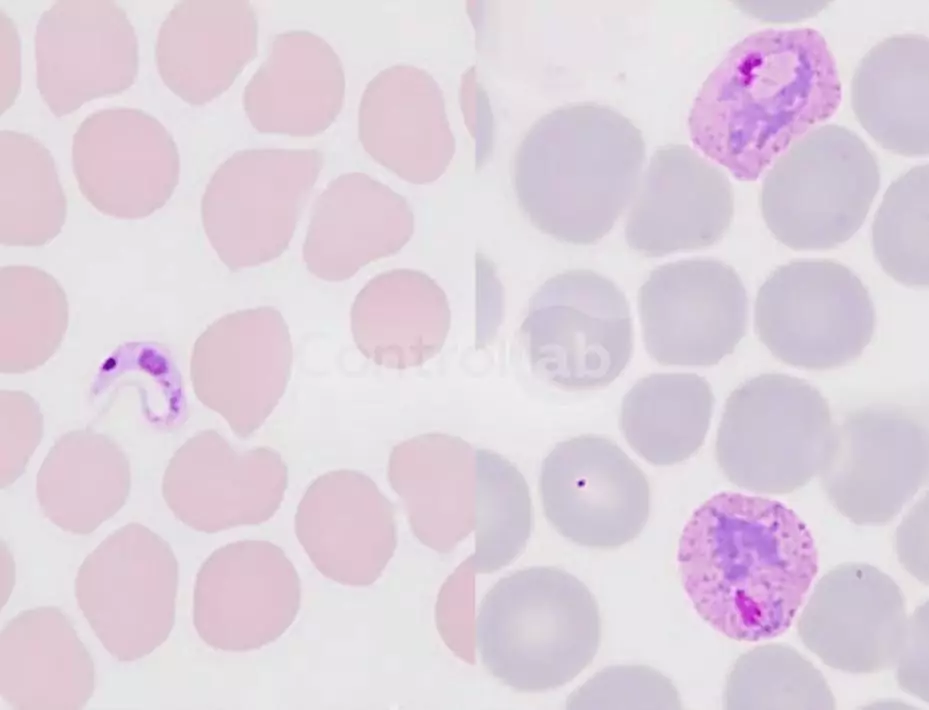
Hemoparasitologia

Identificación de Género y Especie.
Ensayo de Aptitud
- Ítems digitalizados de frotis de sangre humana teñidos.
- Identificación de hemoparásitos como Babesia sp., Bartonella sp., Leishmania sp., Microfilaria sp., Plasmodium sp., Toxoplasma sp y Trypanosoma sp.
- Cualitativo.
Programas disponibles:
- Hemoparasitología (3 Ítems x 4 Rondas) – EPHT34 | EP043
Consulte los ensayos acreditados según el alcance publicado en www.gov.br/inmetro
Programas Relacionados
-
CL
Hematoscopia
Hematoscopia I Basófilos Bastones Neutrófilos Blastocitos (células inmaduras) Eosinófilos Eritroblastos Identificación Celular Linfocitos Metamielocitos Neutrófilos Mielocitos Neutrófilos Monocitos Morfología de la Serie Roja Neutrófilos Segmentados Otras […]
EPCLÍNICO